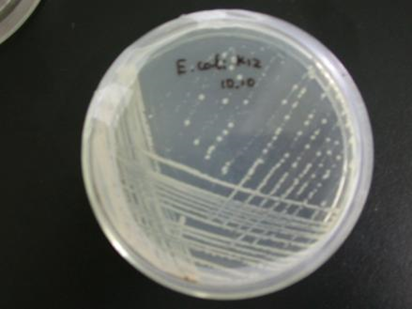

实验结果观察与分析
上一节
下一节
全班同学共同做1个原始土壤样品溶液。共同分配培养基。
混合式教学:
每大组拿到2瓶牛肉膏蛋白胨培养基、1瓶PDA、1瓶高氏1号;每瓶可以倒8~10块平板。组内分配任务,每小组(2人)倒1瓶培养基制备平板。每个小组将进行6块平板的涂布和2块平板的划线。
每一大组内成员共享实验结果。将各自负责的培养基照片拍照发给同一组内的其他成员。实验报告应讨论细菌、真菌和放线菌的情况。
课后任务:实验结果的观察与记录;观察结束应收拾好作用物品。

五、注意事项
1.一般土壤中,细菌最多,放线菌及霉菌次之.而酵母菌主要见于果园及菜园土壤中,故从土壤个分离细菌时,要取较高的稀释度,否则菌落达成一片不能计数。
2.在土壤稀释分离操作中,每稀释10倍,最好更换一次移液管,使计数准确。
3.放线菌的培养时间较长,故制平板的培养基用量可适当增多。
六、实验报告
1. 记录土壤稀释分离结果,并计算出每克土壤中的细菌、放线菌和霉菌的数量。

计算方法:选择长出菌落数30-300之间的培养皿进行计数, 按以下公式:
总菌数/g=同一稀释度几次重复的菌落平均数×稀释倍数
七、问题和思考
1.在测定土壤微生物含量中,除涂布法外还用什么方法?
挑战思考题:试设计实验,从茶叶中分离出霉菌。


